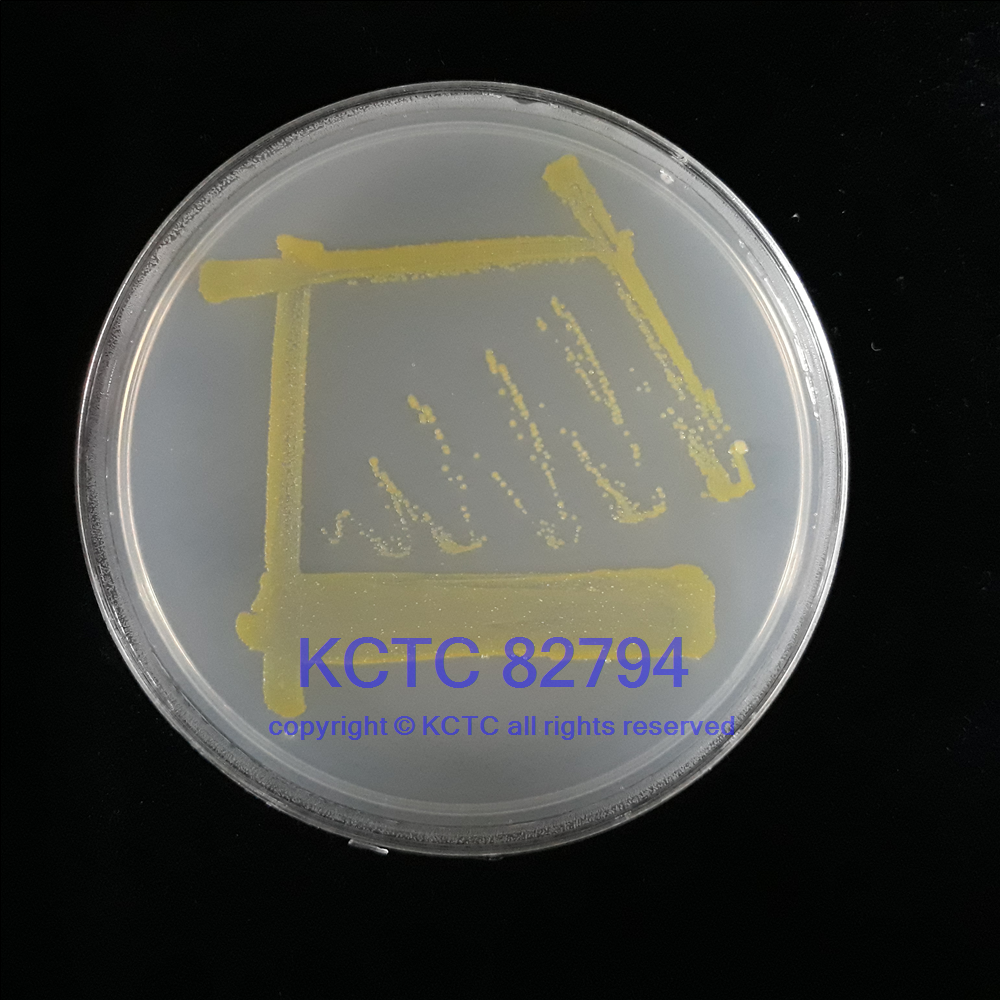

KCTC 82794
JCM [16711], DSM [27062], KCCM [42951]
培養(yǎng)基編號:33
培養(yǎng)溫度:30
用途:
來源:
分離源:
培養(yǎng)基信息
培養(yǎng)基編號:33
名稱:LB Medium (LB 培養(yǎng)基)
配方文檔:
推薦生產(chǎn)廠家:
價格:
產(chǎn)地:
可用于培養(yǎng)菌種:適用范圍:大腸埃希氏菌(大腸桿菌)
備注:Yeast extact (酵母膏) 5g Peptone (蛋白胨) 10gNaCl 10g Agar (瓊脂) 1-2%Distilled water (蒸餾水) 1000ml pH 7.0